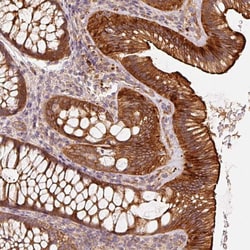

Promotional price valid on web orders only. Your contract pricing may differ. Interested in signing up for a dedicated account number?
Learn More
Learn More
Invitrogen™ CEP95 Polyclonal Antibody


Rabbit Polyclonal Antibody
Supplier: Invitrogen™ PA562607
Description
Immunogen sequence: ALRRHDLLTT LVKKEYEHNK RLQDFKDCIR RQRLTQSKIK ENRQQIVRAR KYYDDYRVQL CAKMMRMRTR EEMIFKKLFE EGLNIQKQRL RDLRNYAKEK RDEQRRRHQD ELDSM Highest antigen sequence identity to the following orthologs: Mouse - 87%, Rat - 87%.
CEP95 gene ontology (GO) annotation includes protein binding and cytoskeleton.
Specifications
| CEP95 | |
| Polyclonal | |
| Unconjugated | |
| CEP95 | |
| 4732496G21Rik; AI118346; AI448335; Ccdc45; centrosomal protein 95; centrosomal protein 95kDa; centrosomal protein of 95 kDa; CEP45; CEP95; coiled-coil domain containing 45; coiled-coil domain-containing protein 45; D330027A14Rik; F630025I20Rik; RGD1309655 | |
| Rabbit | |
| Antigen affinity chromatography | |
| RUO | |
| 90799 | |
| Store at 4°C short term. For long term storage, store at -20°C, avoiding freeze/thaw cycles. | |
| Liquid |
| Immunohistochemistry (Paraffin), Western Blot | |
| 0.3 mg/mL | |
| PBS with 40% glycerol and 0.02% sodium azide; pH 7.2 | |
| Q96GE4 | |
| CEP95 | |
| Recombinant protein corresponding to Human CEP95. Recombinant protein control fragment (Product #RP-103878). | |
| 100 μL | |
| Primary | |
| Human | |
| Antibody | |
| IgG |
Product Content Correction
Your input is important to us. Please complete this form to provide feedback related to the content on this product.
Product Title
Spot an opportunity for improvement?Share a Content Correction